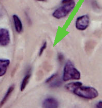

1/201
Looks like no tags are added yet.
Name | Mastery | Learn | Test | Matching | Spaced | Call with Kai |
|---|
No analytics yet
Send a link to your students to track their progress
How do animals regualte their internal state even in changing or harsh envrioments?
Adaptations in form, function and behavior help maintain an animal’s internal enviroment.
In the context of an animal regulating their internal state, what does form mean?
anatomy (biological structure); insulating reduces heat loss

In the context of an animal regulating their internal state, what does function mean?
physiology; shivering produces heat

In the context of an animal regulating their internal state, what does behavior mean?
reaction; packing together reduces exposure (to harsh weather)

What are some of the functions that nutrients and oxygen provide animals?
They help animals: fight off infections, survive, produce offsprings
How is an animals’s strucutre and funcrtion correlated?
form fits function; evolution shapes an animal’s body structures so they can perform the functions necessary for survival and reproduction.
What is the point of examining an animal’s anatomy?
It often provides clues to physiology (biological function)
What are some examples of strucutre-function correlations in birds?
The bones in their wings are hollow, which lightens their weight, allowing them to fly more efficiently
What part of the gecko allows them to walk up a wall and across ceilings?
The structure of the gecko’s feet leads to a unique function; on a singular toe, there are (millions of) rows of setae on a gecko’s foot with (billlions of) spatular coming from a single setae

Van der Waals forces
Molecularly smooth hydrophobic surfaces adhere to each other or to other hydrophobic substances through van der Waals forces and hydrophobic forces
In water, the hydrophobic effect, a thermodynamically driven phenomenon, causes water molecules to minimize contact with the hydrophobic surfaces, favoring the surfaces' close approach and creating strong attractive forces.
Using geckos, explain how its ability to walk on walls and across ceilings demonstrates Van der Waals force?
As it adheres to molecularly smooth hydrophobic GaAs semiconductor. the strong adhesion between the hydrophobic surfacae of the gecko’s toes and the hydrophobic GaAs surfaces demonstrates that the mechanism of adhesion in geckos is Van der Waals force

In what conditions do van der Waals forces apply?
In air or very dry conditions, van der Waals forces are a primary mechanism for the adhesion of two molecularly smooth, hydrophobic surfaces.
What is the rate of exchange proportional to?
A cell’s surface area
What is the amount of material exchanged proportional to?
A cell’s volume
What are the differences in teh SA:V ration in small cells vs big cells?
small cells have a high SA:V ratio, facilitating efficient diffusion, while large cells have a low SA:V ratio, slowing material exchange
Explain the reasoning behind why large cells have a low SA:V ratio
its volume increases faster than its surface area, leading to a decreased SA:V ratio and less efficient transport.
A low SA:V ratio slows down diffusion, making it difficult for a large cell to get enough nutrients and remove enough waste to survive, thus limiting cell size.
Why must cells maintain a high SA:V ratio?
It allows for efficient exchange of materials across the cell membrane. Cells must maintain a high SA:V ratio to survive, which is why they typically divide to stay small.
How does having a complex body plan help an animal living in a variable enviroment?
It helps the animal maintain a relatively stable internal enviroment
What is the function of interstitial fluids?
Interstitial fluids fill the space between cells which links exchange surfaces to body cells
Tissues
groups of cells with a similar appearance and a common function
(tissues makes up ograns, organ make up organ systems)
Emergent properties
a characteristic of the system as a whole; emergence is a result of how components interact, not just what those components are. The property is absent when you examine the individual components on their own
Give an example of a hierarchical organization of body plan
Cellular level: muscle cell
Tissue level: muscle tissue
Organ level: heart
Organ system level: circulartory system
Organism level: many organ systems functioning together
What are the main components of the digestive system?
mouth, pharyx, esophagus, stomach, intestines, liver, pancreas, anus
What are the main functions of the digestive system?
food processing: injestion, digestion, abosrption, elimination
What are the main components of the circulatory system?
heart, blood vessels, blood
What is the main function of the ciruclatory system?
Internal distrubution of materials
What are the main components of the respiratory system?
lungs, trachea, other breathing tubes
What is the main functions of the respiratory system?
gas exchange (intake of O2, disposal of CO2)
What are the main compononets of the immune and lymphatic system?
bone marrow, lymp nodes, thymus, spleen, lymph vessles
What is the main function of the immune and lymphatic system?
body defense (fighting infections and virally induced cancers)
What are the main components of the excretory sytem?
kisney, ureters, urinary bladdder, urethra
What are the main functions of the excretory system?
disposal of metabolic wastes; regulation of osmotic balance of blood
What are the main components of the endocrine system?
pituitary, thyroid, pancreas, adrenal gland, and other horomone secreting glandshormone-secreting
What is the main function of the endocrine system?
coordination of body activities (such as digestion and metabolism)
What are the main components of the reproductive system of females?
uterus, ovaries, fallopian tube, oviduct, vaginal opening, cllitoris, labia, external vulva,
What are the main components of the reproductive system of males?
testes, epididymus, scrotum, vas deferens, seminal vesicles, prostate gland, urethra, penis
What are the main function of the reproductive system of females and males?
Female: gamate production; promotion of fertilization; support of developing embryo
Male: assists in fertilization, make sperm
What are the main components of the nervous system?
brain, spinal cord, nerves, sensroy organs
What are the main functions of the nervous system?
coordination of body activites; detection of stimuli and formulation of responses to them
What are the main components of the integumentary system?
Skin and its derivaties (such as hair, claws, sweat glands)
What are the main functions of the integrumentary system?
Protection against mechanical injury, infection, dehydration; thermoregulation
What are the main components of the skeletal system?
skeleton (bones, tendons, ligaments, cartilage)
What are the main functions of the skeletal system?
body support, protection of intenrla organs, movement
What are the main components of the muscular system?
skeletal muscles
What are the mian function of the muscuar system?
locomotion and other movement
Histology
the study of the microscopic anatomy of cells and tissues
What are the 4 main types of animal tisssues?
Epithelial, connective, muscle, nervous
Epithelial tissue
contians cells that are closely joined
has an apical and basal surface
Aprical surface of epithelial tissue
Faces the open space, lumen, or external environmen
Basal surface of epithelial tissue
the side of the epithelial cells that is anchored to a basement membrane, a specialized layer separating the epithelium from underlying connective tissues
What are some characteristic of the covering/lining epithelium?
covers the outside of the body
lines organs and cavities within the body
contains cells that are closely joined
can come form any of the 3 germ layers
possess remarkable regenerative powers; replacing cells throguhout life
What is the derivative of epithelia?
glands
What are some characteristics of the exocrine gland?
connecting cells persist to form a duct
deepest cells become secretory

What are some characteristics of the exocrine gland?
connecting cells disappear
deepest cells remain to secret into capillaries

What are 5 general functions of the epithelium?
provide pysical protection (skin)
control permeability (endothelium, lung)
provide absorption (GI tract)
produce specialized secretions (glands)
provide sensitivity (sensory epithelium)
What are the 4 general types of epithelial tissues?
simple, stratified, pseudostratified, transitional
What are the 3 types of simple epithelial tissues?
squamous, cubodial, columnar

What is an example of pseudostratified epithelial tissue?
pseudostratified cillated columnar
What does simple squamous epithelial tissue look like?
Squamous epithelial tissue has a very flat, thin, and scale-like, broad, with irregular edges, and with a central, flattened nucleus.
Where is simple squamous epithelial tissue located?
Lining of blood vessels and lymphatic vessels (endothelium)
Lining of body cavities (mesothelium) such as pleura, pericardium, and peritoneum
Air sacs of the lungs (alveoli)
Bowman’s capsule of the kidney
What is the function of simple squamous epithelial tissue?
Diffusion, filtration, and smooth lining to reduce friction.
What does simple cuboidal epithelial tissue look like?
A single layer of cube-like cells with round nuclei. about as tall as they are wide, with a round, centrally located nucleus
under the microscope, they look like tiny boxes/dice

Where is simple cuboidal epithelial tissue located?
found in places where the body needs secretion, absorption, or protective lining
Kidney tubules → for absorption and secretion of substances
Small gland ducts → salivary glands, pancreas, thyroid follicles (secreting hormones like thyroxine)
Surface of the ovary (germinal epithelium)
What is the function of simple cuoidal epithelial tissue?
Secretion → e.g., secretes hormones in the thyroid, enzymes in glands.
Absorption → e.g., reabsorbs substances in kidney tubules.
Lining/Protection → provides a smooth lining in ducts and small tubules.
What does simple columnar epithelail tissue look like?
single layer of tall, rectangular cells, much taller than they are wide, like bricks standing on end. Cells are elongated, with oval nuclei located near the base.

Where is simple cilisted/non-ciliated columnar epithelial tissue location?
where the body needs absorption, secretion, or movement of substances
Non-ciliated simple columnar epithelium → stomach, intestines, gallbladder → mainly for absorption and secretion
Ciliated simple columnar epithelium → uterine tubes, uterus, parts of respiratory tract → for movement of mucus or eggs
What are the general functions of simple columnar epithelial tissue?
absorbs nutrients, secretes mucus and enzymes, and moves substances when cilia are present.

What are the more specific functions of simple columnar epithelial tissue?
Absorption → in the small intestine, microvilli increase surface area to absorb nutrients.
Secretion → goblet cells release mucus to lubricate and protect (e.g., in stomach and intestines).
Movement → cilia on columnar cells help move substances:
Move eggs through the uterine tubes
Move mucus in parts of the respiratory tract
Protection → the tall cells form a barrier against bacteria and chemical stress in the gut.
What does pseudostratified ciliated columnar look like?
The cells are all tall and columna,
Looks like multiple layers, but actually just one
Nuclei at different heights → “messy, staggered” look.
Has cilia on the surface + mucus-secreting goblet cells.

Where is pseudostratified ciliated columnar located?
Usually in respiratory tract:
Trachea
Bronchi (large airways of the lungs)
Nasal cavity
Parts of the larynx
What is the function of pseudostratified ciliated columnar?
a self-cleaning lining of the respiratory tract → mucus traps particles, cilia sweep them away.
What are the 3 types of stratified epithelial tissues?
squamous, cubodial, columnar
What does stratified squamous epithelial tissue look like?
Thick, multilayered sheet.
Bottom = plump cells, top = flat squamous cells.
Looks like a “layer cake,” with the top layer being thin and flat.

Where is stratisfied squamous epithelial tissue located?
where the body needs protection against friction, abrasion, and pathogens.
Keratinized stratified squamous epithelium: surface cells are dead, no nuclei —> (tough, dry, waterproof)
Epidermis of the skin
2. Non-keratinized stratified squamous epithelium: surface cells are alive, with nuclei —> (moist, protective lining)
Mouth (oral cavity)
Esophagus
Vagina
Anal canal
What is the function of stratified squamous epithelial tissue?
thick, multilayered shield that protects the body in both dry (skin) and moist (mouth, esophagus, vagina) environments.
What does stratified cuboidal epithelial tissue look like?
two or more layers of cube-shaped cells
The basal layer may be cuboidal or sometimes columnar.
The apical (surface) layer is distinctly cuboidal: square-shaped cells with round, centrally placed nuclei.

Where is stratified cuboidal epithelial tissue located?
Ducts of sweat glands
Ducts of mammary glands
Ducts of salivary glands
Sometimes in parts of the male urethra
What is the function of stratified cuboidal eipthelial tissue?
protective lining for ducts that also aids in secretion and stability
Protection → the multiple layers make ducts stronger and more resistant to damage.
Secretion → helps glands release substances (like sweat, saliva, or milk).
Structural support → reinforces the walls of larger ducts so they don’t collapse.
What does stratified columnar epithelial tissue look like?
looks like a layered sheet where the top row is tall “columns”, sitting on shorter cells underneath.
Basal layers: usually cuboidal or shorter cells that anchor the tissue.
Apical (top) layer: elongated, rectangular columnar cells with oval nuclei near the base.

Where is stratified columnar epithelial tissue located?
places that need protection plus secretion.
Male urethra (parts)
Large ducts of some glands (salivary glands, mammary glands)
Pharynx (throat)
Conjunctiva of the eye
What is the function of stratified colunmar epithelial tissue"?
Protection → the multiple layers protect underlying tissues in ducts, urethra, and pharynx.
Secretion → the columnar surface cells help secrete mucus and other substances in gland ducts.
Structural support → reinforces walls of larger ducts and passages.
What are the two types of transitional epithelial tissue?
relaxed and distended
What is the difference between relazed and distended transitional epithelial tissue?
Relaxed = dome-shaped surface cells, thick layers (empty bladder)
Distended = flattened surface cells, thinner layers (full bladder)

Where is transitional epithelial tissue located?
only found in the urinary system, where tissues need to stretch and recoil without tearing
bladder
ureters
What is the function of transitional epithelial tissue?
stretchy, protective lining of the urinary system; let organs in the urinary system stretch and recoil safely while still forming a protective barrier.
What is the function of connective tissue?
hold many tissues and organs together and in place
storage, transport, protection, repair
What are some characteristics of connective tissue?
contains sparsely packed cells scattered throughout an extracellular matrix which consists of fibers in a liquid, jellylike, or solid foundation (ground substance)
What are the components of CT?
Cells, fibers, ground substance
What are some parts of cells in CT?
fibroblasts (fibrocytes)
macrophages
mast cells
plasma cells
leukocytes
fat cells
What are the 3 types of fibers in CT?
collagenous, elastic, reticular
What does loose collagenous fibers look like?
thick, wavy, pale-pink strands (when stained with H&E), running in many directions.
irregular and loosely packed, not parallel → gives the tissue flexibility.

What is the funcrion of loose collagenous fiber?
Support & binding → holds organs, blood vessels, and nerves in place.
Flexibility → fibers are loosely arranged, so the tissue is soft and flexible.
Cushioning → provides padding and protects delicate structures.
Diffusion medium → allows nutrients, oxygen, and waste products to move between blood and surrounding cells.
Immune defense → contains immune cells (macrophages, mast cells) that respond to infections.
Where are loose collagenous fibers located?
Under the skin (just beneath the epithelium, in the dermis and subcutaneous layer).
Around blood vessels and nerves → acts like a protective sheath.
Between muscles → fills spaces and prevents friction.
Around organs (like kidneys, intestines) → holds them in place.
Mucous membranes → underlying lamina propria of respiratory and digestive tracts.
What does loose elastic fiber look like?
thin, dark-staining, thread-like lines that weave between the thicker collagen fibers; arranged in a loose, irregular network → gives the tissue elasticity.

Where are loose elastic fibers located?
anywhere tissues need to be stretchy and resilient
Skin (dermis, especially papillary layer) → gives skin flexibility.
Lungs → allow expansion and recoil during breathing.
Walls of blood vessels (especially arteries) → help vessels stretch and return to shape with blood pressure changes.
Around organs → interwoven with collagen in areolar tissue, providing elasticity to support structures.
What is the function of loose elastic fibers?
thin, stretchy threads that make tissues flexible and able to bounce back after stretching.
What does loose retibular fibers look like?
very thin, delicate fibers that form a branching network instead of thick bundles like collagen or wavy threads like elastic fibers (like spider-webs)

Where are loose retibular fibers located?
“support net” inside the immune and blood-forming organs.
Lymphoid organs → lymph nodes, spleen, tonsils
Bone marrow → supports developing blood cells
Liver → forms a framework around hepatocytes and sinusoids
Endocrine glands → support secretory cells
Basement membranes (reticular lamina) → help anchor epithelium to underlying connective tissue
What are the functions of loose retibular fibers?
a supportive net that provides structure without rigidity, especially in lymphoid organs, bone marrow, and liver.
What is ground substance of CT?
made and secreted by fibroblasts; hydrated gel in connective tissue that supports, cushions, and allows diffusion of nutrients/waste while embedding fibers and cells.